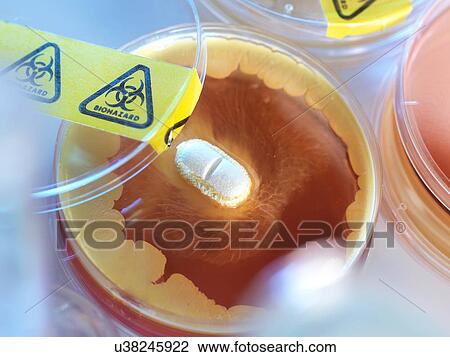

Fotosearch Royalty Free Stock Photography
Digital images licensed by Publitek, Inc.
Fotosearch and Photosearch are trademarks of Fotosearch, LLC
All rights reserved © 2026-03-10
Antibiotic testing Drawing
Antibiotic testing
u38245922 | Lushpix Illustration | Royalty Free
Add to Lightbox
Share Image
Keywords
antibiotic resistance, antibiotics, bacteria, biohazard, biology, biomedical, close up, culture, cultures, day, detail, drug resistance, drug testing, health, healthcare, indoors, lab, laboratory, medical, medicine, microbiology, mrsa, pathogen, petri dish, pharmaceutical, research, superbug, stock illustration, royalty free illustrations, stock clip art icon, stock clipart icons, logo, line art, EPS picture, pictures, graphic, graphics, drawing, drawings, vector image, artwork, EPS vector arts, fine art prints, print, poster, posters, mural, wall murals, u38245922
antibiotic resistance, antibiotics, bacteria, biohazard, biology, biomedical, close up, culture, cultures, day, detail, drug resistance, drug testing, health, healthcare, indoors, lab, laboratory, medical, medicine, microbiology, mrsa, pathogen, petri dish, pharmaceutical, research, superbug, stock illustration, royalty free illustrations, stock clip art icon, stock clipart icons, logo, line art, EPS picture, pictures, graphic, graphics, drawing, drawings, vector image, artwork, EPS vector arts, fine art prints, print, poster, posters, mural, wall murals, u38245922
Show Keywords
- Mobile/Small Web Resolution (150 KB)3.7" x 2.8" @ 72dpi JPG13
- Web Resolution (500 KB)6.7" x 5" @ 72dpi JPG32
- Low Resolution (1 MB)9.5" x 7.1" @ 72dpi JPG68
- Medium Resolution (10 MB)7.2" x 5.4" @ 300dpi JPG140
- High Resolution (28 MB)12" x 9" @ 300dpi JPG215
- Ultra High Resolution (50 MB)16.1" x 12.1" @ 300dpi JPG250
View larger image sizes
View Lushpix Illustration license agreement

